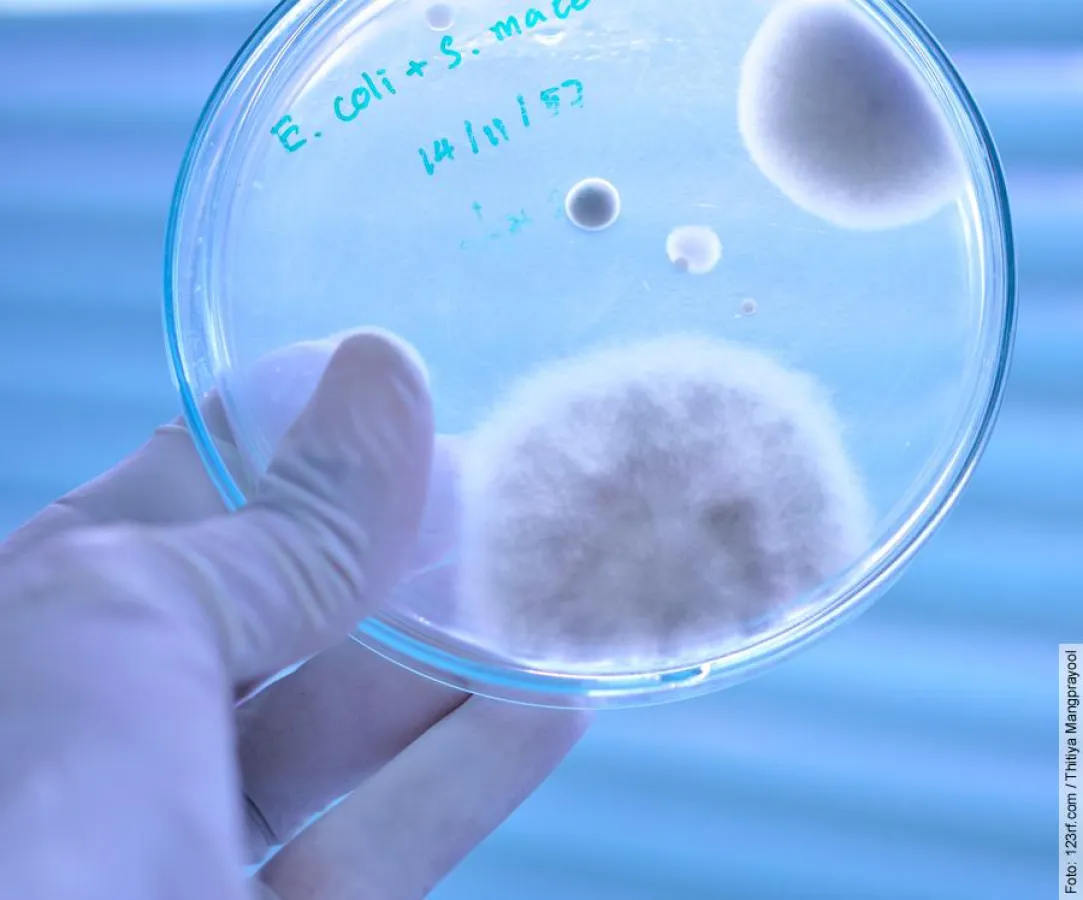
Penicillin und Insulin wurden ohne Tierversuche entdeckt

(openPR) (Reinach/Bonaduz) Behauptungen der Tierversuchsbefürworter sind widerlegbar
Wie diverse Quellen belegen, sind Medikamente, wie zum Beispiel Penicillin und Insulin, ohne Tierversuche entdeckt worden. Trotzdem halten Tierversuchsbefürworter an ihrer Behauptung fest, gerade die wichtigen Arzneien Penicillin und Insulin hätten wir Tierversuchen zu verdanken.
Die Aktionsgemeinschaft Schweizer Tierversuchsgegner, kurz AG STG, verlangt, dass Pro-Tierversuchsorganisationen diesen Sachverhalt richtigstellen.
Wie die englische Organisation «For Life On Earth» kürzlich publik machte, bemüht sie sich seit Jahren vergeblich darum, die englische Pro-Tierversuchsorganisation «Understanding Animal Research (UAR)» zur Teilnahme an einer Medizinischen Anhörung zu bewegen. Dabei soll klargestellt werden, dass ihre Behauptung, ohne Tierversuche gäbe es weder die Arznei Penicillin noch Insulin, falsch ist. «For Life On Earth» berichtet: «Seit 2 Jahren rufen wir die UAR dazu auf, an einer medizinischen Anhörung teilzunehmen (...). Kein Wissenschaftler der UAR hat sich auf eine Medizinische Anhörung vor unabhängigen sachkompetenten ‹Richtern›, welche somit qualifiziert wären ein Urteil zu fällen, eingelassen».
Verschiedene Quellen belegen nicht nur, dass die beiden Arzneien unabhängig vom Tierversuch entdeckt worden sind, sondern auch, dass die anschliessend durchgeführten Tierversuche den Einsatz dieser Medikamente beinahe verhindert hätten. Die Tierversuchsergebnisse verleiteten die damaligen Forscher zur Annahme, dass Penicillin und Insulin als Arzneien ungeeignet sind. Erst durch die Anwendung der beiden Stoffe am Menschen und – im Falle von Insulin, die Weiterverarbeitung mit in-vitro-Techniken – erkannte man, dass Penicillin und Insulin als wertvolle Humanarzneien eingesetzt werden können.
Wie bereits zu den Zeiten der Entdeckung von Penicillin und Insulin, ist es auch heute noch üblich, dass die meisten medizinischen Entdeckungen im Tierversuch überprüft werden. Stellt sich in den anschliessenden Untersuchungen am Menschen (z.B. klinische Studien) heraus, dass die Entdeckung einen Nutzen für den Menschen hat, wird der Erfolg den vorausgegangenen Tierversuchen zugerechnet. Dr. Ray Greek sagt dazu: «Tierversuchen die Entdeckung von Insulin anzurechnen, ist vergleichbar damit, dem Toyotaverkäufer für die Erfindung des Autos zu danken».
Die Aktionsgemeinschaft Schweizer Tierversuchsgegner, kurz AG STG, begrüsst das Bestreben von «For Life On Earth» «UAR» zu einer Erklärung aufzufordern. «John Macleod, welcher durch seine Tierversuche an Hunden als Mitentdecker des Insulins gilt und dafür einen Nobelpreis erhielt, gab selbst zu, dass sein Beitrag nicht das Entdecken des Insulins, sondern das Reproduzieren von Ergebnissen, wie man sie bereits aus Untersuchungen am Menschen kannte, war.», sagt Marietta Haller, wissenschafliche Mitarbeiterin der AG STG. Fehlinformationen, wie die, dass wir die Medikamente Penicillin und Insulin Tierversuchen zu verdanken hätten, sind mit daran schuld, dass Tierversuche noch heute grosse Akzeptanz in der Bevölkerung finden.
Quelle und weitere Informationen:
http://www.forlifeonearth.org
Die Broschüre «Die Medizin der Zukunft – Die Möglichkeiten der tierversuchsfreien Forschung» finden Sie als PDF unter: http://www.agstg.ch/downloads/flyer/agstg-prospekt_medizin-der-zukunft-tierversuchsfreie-forschung_de.pdf